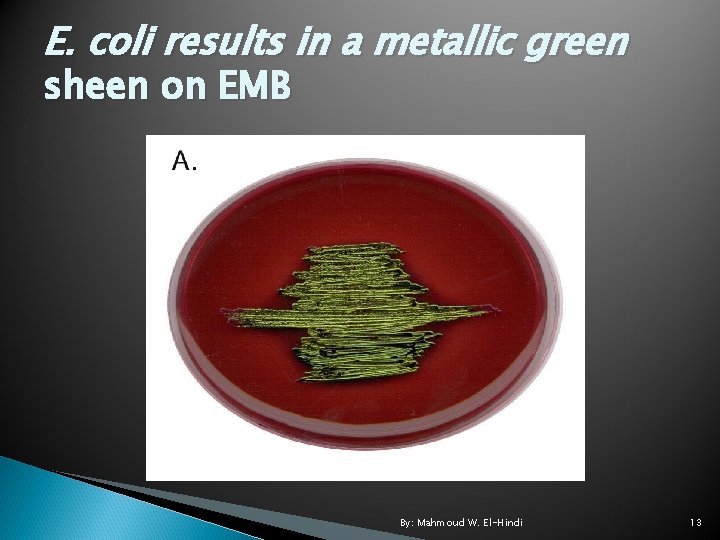
E. coli results in a metallic green sheen on EMB By: Mahmoud W. El-Hindi
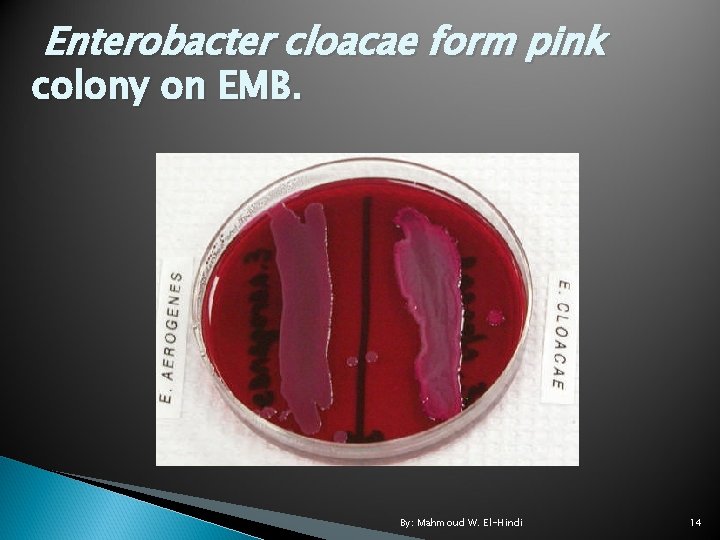
Enterobacter cloacae form pink colony on EMB. By: Mahmoud W. El-Hindi 14

Microbiology Lab Selective and differential Media By Mahmoud

Microbiology Lab Selective and differential Media By: Mahmoud W. El-Hindi 1

Introduction In addition to general-purpose media, which allow the growth of most types of bacteria, microbiologists use specialized media to identify and/or isolate specific groups of bacteria. In this experiment, we will use differential and selective media. By: Mahmoud W. El-Hindi 2

Cont. Selective media are used to isolate specific groups of bacteria. These usually contain inhibitors which prevent the growth of unwanted bacteria, while allowing the growth of the desired bacteria. Differential media allow microbiologists to distinguish between biochemical and morphologically related groups of bacteria. By: Mahmoud W. El-Hindi 3

Cont. These media incorporate chemicals that produce some characteristic change in the colonies or media around the colonies of specific types of bacteria within the group. Often, selective and differential capabilities are incorporated into a single medium. By: Mahmoud W. El-Hindi 4

Mannitol salt agar (MSA) Contains 7. 5% Na. Cl, a salt level which is toxic to most bacteria except the genus Staphylococcus. This is the selective portion of the medium. MSA is also differential. It contains the carbohydrate, mannitol, as well as the p. H indicator, phenol red. Staphylococci that ferment mannitol and produce acid exhibit a yellow color around their colonies. Staphylococci that do not ferment mannitol do not produce a color change from the normal redpink color of the medium. By: Mahmoud W. El-Hindi 5

Staphylococcus aureus yellow color By: Mahmoud W. El-Hindi 6

Mac. Conkey agar (Mac) Is used for the isolation of Gram negative organisms. It contains crystal violet, which inhibits the growth of Gram positive organisms and also gives the medium a light pink-lavender color. The medium also contains bile salts, lactose, and the p. H indicator, neutral red. As well as being selective for Gram negative, Mac is differential within that group. By: Mahmoud W. El-Hindi 7

Cont. Coliform bacilli produce acid from lactose fermentation causing the colonies to turn red from the p. H indicator. E. coli produces even greater quantities of acid causing the surrounding medium and the colonies to turn pink. Non-coliform bacilli do not ferment lactose, and appear uncolored or transparent on Mac. By: Mahmoud W. El-Hindi 8

Color of lactose fermenters. By: Mahmoud W. El-Hindi 9

Cont. By: Mahmoud W. El-Hindi 10

Levine's eosin-methylene blue agar (EMB) Is primarily a differential medium. However, it does inhibit the growth of some Gram positive bacteria. EMB is used to differentiate between enteric lactose fermenters (coliforms) and nonlactose fermenters as well as specifically identifying E. coli. It is often used to confirm the results of tests with Mac. Conkey agar. By: Mahmoud W. El-Hindi 11

Cont. The eosin and methylene blue dyes cause lactose fermenters to have pink colonies. E. coli incorporates so much of the dye that the dyes precipitate in the cells and give the colonies a metallic green sheen. Non-lactose fermenters are usually transparent and take on the purple color of the medium. By: Mahmoud W. El-Hindi 12
E. coli results in a metallic green sheen on EMB By: Mahmoud W. El-Hindi 13
Enterobacter cloacae form pink colony on EMB. By: Mahmoud W. El-Hindi 14

Materials Each student/team: 1 Mannitol salt agar plate. 1 Mac. Conkey agar plate. 1 Eosin-methylene blue plate. By: Mahmoud W. El-Hindi 15

Lab supplies: Nutrient broth cultures of Salmonella typhimurium, Escherichia coli, Enterococcus (Streptococcus) faecalis and Staphylococcus aureus (all 24 - to 48 -hour). By: Mahmoud W. El-Hindi 16

Methods 1. Using a grease pencil or marker, divide the bottom of each of the listed plates into four sections. 2. Using a loop and proper sterile technique, inoculate each plate with E. coli, Staphylococcus aureus, Salmonella typhimurium and Streptococcus sp. using a single streak. 3. Incubate all of the plates at 37°C for 48 hours. Record the results. By: Mahmoud W. El-Hindi 17

My Best Wishes By: Mahmoud W. El-Hindi 18
- Slides: 18